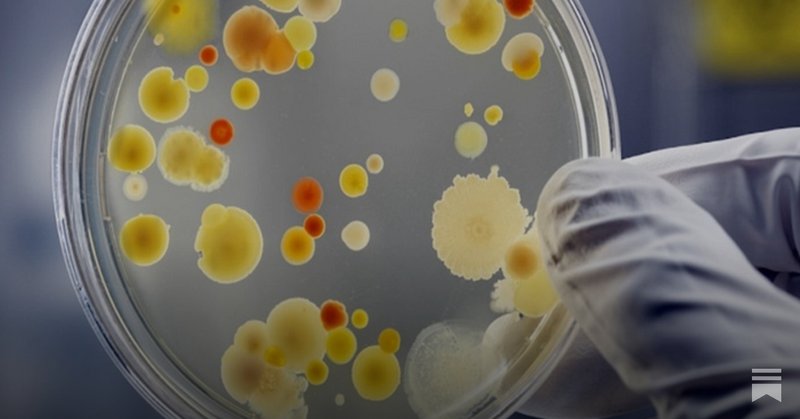
Tweet card summary image

Shobha Shukla ❇️ शोभा शुक्ला
@shobha1shukla
Followers
3K
Following
7K
Media
1K
Statuses
9K
Feminist & Founder ED & Managing Editor @CNS_Health; Host SHE & Rights; Chairperson, Global AMR Media Alliance @globalAMRmedia; APCAT Media; ex-faculty Loreto
India/ UK
Joined June 2009
Listen to TB survivor Jahangeer of @Humana_India on critical role of HPPI person-centred model to support & link unhoused or homeless persons with TB services https://t.co/2Q5UvX5pFp
#endTB #UnhousedNotUnseen #TBMuktBharat #TBMuktBharatAbhiyan #TBHaregaDeshJeetega #TBFreeIndia
0
0
0
From shadow to light: Supporting unhoused persons to access lifesaving TB services https://t.co/wQwZXDs57w
dailygoodmorningkashmir.com
Linkage to local community people also proved important because location of unhoused persons kept changing on an ongoing basis.
0
1
1
At the🇳🇵UPR Pre-Session in Geneva, our Founding Chair @LaxmanKasyap, urged to reform restrictive media laws, ensure justice & protection for journalists, safeguard digital rights & strengthen gender equality in newsrooms. 👉 https://t.co/D12yoZ9llY
0
2
2
I am flying over #BlackSea. Thanks #VirginAtlantic for comfortable premium economy and special considerations. @VirginAtlantic
0
0
1
The clock is ticking to #endAIDS⏰ This #WorldAIDSDay learn why we must #StopTheHIVClock➡️ https://t.co/vdweK5kIhH A campaign by the @sevenallianceap & @UNAIDS_AP starring #HouseOfTayTay & @mariaehren Stay tuned...🔜👀⏳@UNAIDS @Winnie_Byanyima @gnpplus @WHOWPRO @iasociety
1
9
12
#CitizenNewsService #CNS #TB #ShobhaShukla #BobbyRamakant @shobha1shukla @BobbyRamakant Supporting homeless or unhoused persons and migrants to access lifesaving TB services... https://t.co/LGK2YtLTW3
0
4
5
Antimicrobial resistance is rising faster than new treatments can keep up. This earlier story by @shobha1shukla remains a stark warning for global public health today.
asiasentinel.com
Antimicrobial resistance is not a silent pandemic
0
5
6
#Antimicrobialresistance is a growing crisis, but India is addressing it through coordinated, evidence-based action to preserve the effectiveness of lifesaving medicines. @ICMRDELHI
@mdncdc
@MoHFW_INDIA @CDSCO_INDIA_IN
Listen to Dr @KaminiWalia head of #AntimicrobialResistance & among top scientists @ICMRdelhi in conversation w @AnubhaBhonsle India launched revised National #AMR Action Plan a week ago. Science- & evidence-based, data-driven policy & partnerships-based https://t.co/4c2ubVHAps
0
3
6
⏰ The day is HERE! Meet the HIV Clock at the Asia-Pacific 2025 #WorldAIDSDay report & #StopTheHIVClock launch Register now and join us at 1PM Bangkok time (GMT+7) for a reality check and a mission: https://t.co/sNpOcGumte
0
6
14
कल्पना कीजिए कि 97 साल पहले उन लोगों का क्या हाल होता होगा जो बीमार थे परंतु दवा का इजा�� ही नहीं हुआ था। एंटीमाइक्रोबियल दवा आने के बाद अनेक लाइलाज संक्रमणों का इलाज आसान हो गया पर #AntimicrobialResistance का बढ़ता ख़तरा स्वास्थ्य सुरक्षा पर मंडरा रहा है https://t.co/hcq3lzJUmt
0
0
0
Day 3 — the final day of #MOP4. After three days of deliberations, the Meeting of the Parties is now moving toward its conclusion, shaping key decisions to advance the implementation of the Protocol to Eliminate Illicit Trade in Tobacco Products. https://t.co/CS13aFNTgD
1
2
9
Listen to Dr @KaminiWalia head of #AntimicrobialResistance & among top scientists @ICMRdelhi in conversation w @AnubhaBhonsle India launched revised National #AMR Action Plan a week ago. Science- & evidence-based, data-driven policy & partnerships-based https://t.co/4c2ubVHAps
0
1
0
#PublishedToday Latest @WHO Global TB Report 2025 shows #TOBACCO is among top-5 risk factors for #TB But have TB & tobacco control prog. joined hands? Insights: @Bam_Tara of @VitalStrat, @Rakesh1953 & more 🌻 Daily GMK https://t.co/bGQ2lDJp0g 🌻 C N S https://t.co/mdXJVDxJTu
0
0
0
@shobha1shukla @WHO @bam_tara @VitalStrat @GCRF_TCCP @FDATobacco @TC_BMJ @TBHDJ @StopTB @TheUnion_TBLH @UnionConference @StopTBIndonesia @StopTBKe @endTB I agree with headline & last para on priority needs to link TbTobacco & health associations/meets to focus on tobacco menace. Advocating for Endgame of Tobacco & non-medical nicotine products by December 2030 and rename NTCP as national tobacco elimination program will be timely
1
1
1
#Part2 #PublishedToday Choice is ours: Do we want to slip back in time when there were not enough medicines around or would we prevent AMR? 🌀The Sangai Express https://t.co/xcj0YNouNf 🌀CNS https://t.co/9d7VYZyXgF
#AntimicrobialResistance #AMR #AntibioticResistance #WAAW2025
0
0
2
Overlooked Risk Factor: How Tobacco is Undermining the Global TB Response Writes: @shobha1shukla
https://t.co/EXb04mZJIm
dailygoodmorningkashmir.com
Tobacco industry interference in public health policy is the biggest obstacle in implementing tobacco control policies.
0
3
4
@getalkslive @bobbyramakant
@shobha1shukla “1 in 3 women continue to experience partner or sexual violence during their lifetime—year after year—with barely any change in this figure since 2000,” says Shobha Shukla, Coordinator and Host of SHE & Rights.
0
3
6
#PublishedToday Latest @WHO Global TB Report 2025 shows #TOBACCO is among top-5 risk factors for #TB But have TB & tobacco control prog. joined hands? Insights: @Bam_Tara of @VitalStrat, @Rakesh1953 & more Central Chronicle https://t.co/HKvk3DTv2k CNS https://t.co/mdXJVDxJTu
1
1
1
Let us begin our day with South Indian Filter Coffee at Adyar when in Chennai
0
0
0